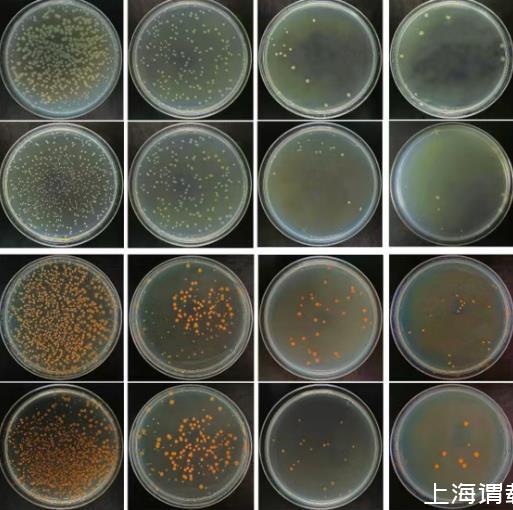

熱線:021-66110810,66110819
手機:13564362870


熱線:021-66110810,66110819
手機:13564362870
隨著工業(yè)水平的不斷發(fā)展與提高,合金材料的使用量亦不斷增大。然而合金材料的腐蝕問題在工業(yè)生產(chǎn)及生態(tài)環(huán)境中造成了不可估量的損失。為此,國內(nèi)外學者已經(jīng)開展了大量關(guān)于合金腐蝕機理與防護方面的研究,并取得了一定的進展。
微電極陣列技術(shù)是一種介于宏觀的經(jīng)典電化學技術(shù)和微區(qū)掃描探針技術(shù)之間的新型電化學測試方法。它既能獲取合金大面積電極的整體平均信息,又能探測合金局部微小區(qū)域內(nèi)的電位、電流分布特征,能更加準確地測試合金局部腐蝕過程中非均一的電化學信息。隨著國內(nèi)外學者的不斷研究與開發(fā),現(xiàn)已實現(xiàn)微電極陣列的優(yōu)化。該技術(shù)聯(lián)合其他電化學測試技術(shù)和表面科學技術(shù)等方法,不斷豐富了合金/腐蝕溶液界面的物理、化學及電化學信息。近幾年,大量專家學者采用該微電極陣列技術(shù)與其他測試技術(shù)相結(jié)合的方法研究了常用合金在不同環(huán)境和腐蝕狀態(tài)下的局部腐蝕過程及機理,并取得了重要的研究進展。其中,對異材質(zhì)金屬的電偶腐蝕行為及演變規(guī)律的研究取得了重大突破。此外,實時耦合的多電極陣列傳感器(CMAS)探針的開發(fā)應(yīng)用,對合金局部腐蝕的在線監(jiān)/檢測起到了舉足輕重的作用。
宏觀的經(jīng)典電化學測試技術(shù)具有一定的局限性,因其研究對象為合金的大面積整體電極,所測實驗數(shù)據(jù)僅能反映電極的整體統(tǒng)計信息,很難準確表征合金腐蝕界面上的電化學不均一性。為準確表征和深入研究合金材料的局部腐蝕過程及機理,尚需尋求一種具有局部分辨度的新型電化學測試方法。微電極陣列技術(shù)因能提供局部不同位置的電位、電流密度的分布和差異等信息,在局部腐蝕研究領(lǐng)域得到了廣泛的應(yīng)用,并取得了很大的研究進展。本文對微電極陣列技、其在研究合金腐蝕環(huán)境的影響、研究進展及應(yīng)用現(xiàn)狀進行了詳細的闡述,并對其進行了總結(jié)和展望。
微生物腐蝕研究
由于海水、土壤等環(huán)境中普遍存在微生物,在該環(huán)境中服役的合金材料表面易被微生物附著而形成一層微生物膜,從而加速了膜下合金的不均勻腐蝕。劉靖等采用微電極陣列技術(shù)研究了硫酸鹽還原菌(SRB)生物膜的電化學不均勻性,結(jié)果表明,SRB生物膜分布的不均勻性可以由電極表面電位隨時間的變化規(guī)律來反映,同時SRB的生長繁殖、新陳代謝進一步促進了生物膜的不均勻性和局部腐蝕的快速發(fā)展。基于劉靖等的研究思路,王偉等利用開路狀態(tài)的微電極陣列技術(shù),即一種基于底部而非表面的測試方法,很好地避免了激勵信號對生物膜層活性的影響,從而可以準確獲取各個微電極上的電化學參數(shù)。這種研究思路也拓展了微電極陣列技術(shù)在微生物腐蝕方面的研究應(yīng)用。Dong等利用微電極陣列技術(shù)研究了SRB對合金腐蝕機制的影響,研究發(fā)現(xiàn)SRB生物膜中含有一定具有導電性的FeS沉積物,致使碳鋼表面電位趨于均勻穩(wěn)定。
考慮到誘發(fā)微生物腐蝕的主要原因之一是不均勻分布的微生物膜,因此近年來一些專家學者利用人工生物膜來模擬并研究了含有某些特殊成分的微生物膜對合金局部腐蝕的影響。例如,張霞等利用微電極陣列技術(shù)研究了過氧化氫對人工模擬的不銹鋼/微生物膜界面的局部腐蝕影響。實驗發(fā)現(xiàn),當加入過氧化氫成分后各短接電極的電位均發(fā)生正移現(xiàn)象,并且在5 min時電位達到最大值。隨時間的延長,還出現(xiàn)了陽極分區(qū)現(xiàn)象。然而,若各電極彼此斷開,則電位正移現(xiàn)象只出現(xiàn)在局部區(qū)域。
緩蝕劑機理研究
隨著微電極陣列技術(shù)及其測控系統(tǒng)的不斷完善,近年來該技術(shù)已較好地應(yīng)用于緩蝕劑對合金的緩蝕機理、無機材料與合金界面局部腐蝕研究中。Naing等用沙子模擬土壤環(huán)境,將碳鋼埋置在3.5%NaCl溶液濕潤的干濕交替土壤環(huán)境中,并用自制微電極陣列測控系統(tǒng)研究了重鉻酸鹽對碳鋼的緩蝕機理。董澤華等采用微電極陣列技術(shù)研究了緩蝕劑在模擬碳化混凝土中對碳鋼局部腐蝕的影響及修復能力,并首次采用局部腐蝕因子的概念,用以定量表征合金的局部腐蝕程度。張國安等采用微電極陣列技術(shù)研究了咪唑啉緩蝕劑對覆蓋在沉積物下的碳鋼油氣輸送管道的緩蝕效果。結(jié)果表明,緩蝕劑對無沉積物覆蓋的碳鋼電極具有較好的緩蝕效果,對覆蓋有沉積物的電極的緩蝕效果較小,但仍具有一定的抑制作用。此后,張國安研究團隊又在碳鋼彎管內(nèi)側(cè)放置微電極陣列,并采用電化學方法研究了油溶性咪唑啉緩蝕劑對彎管流動加速腐蝕的緩蝕效果,探討了緩蝕劑濃度和流體流速對緩蝕作用的影響。蔡光義課題組采用可拆式陣列電極,同時結(jié)合電化學阻抗譜和原子力顯微鏡(AFM)研究高濕含鹽環(huán)境下鋁合金表面侵蝕性及緩蝕性粒子的擴散吸附與相互競爭過程。
不同的海洋環(huán)境研究
沿海合金構(gòu)件的腐蝕行為和規(guī)律受所處特殊海洋環(huán)境的影響,其中大氣/海水界面、海水/海泥界面的腐蝕備受關(guān)注。陳亞林等利用微電極陣列技術(shù)探討了在大氣/海水環(huán)境中水線界面處Q235碳鋼的腐蝕動態(tài)發(fā)展過程。研究發(fā)現(xiàn),該環(huán)境下Q235碳鋼腐蝕的決定性因素為溶氧量,即形成以水線附近為陰極和水線以下為陽極的氧濃差電池。實驗結(jié)果還表明,Q235碳鋼的主要陰極區(qū)處于水線上方,隨著反應(yīng)的進行,合金腐蝕的主要陽極區(qū)逐漸從水線下方擴展至水線處,加速了整個合金的腐蝕速率。微電極陣列技術(shù)較好地體現(xiàn)了整個水線區(qū)的電流分布及其演變信息,對合金在水線區(qū)的腐蝕過程研究提供了有力的支撐。張經(jīng)磊等模擬了海水/海泥躍變區(qū)的鋼鐵電化學腐蝕過程。結(jié)果表明,實驗初期,海水中試樣為主要陽極,海泥中試樣為主要陰極。腐蝕一段時間后,處于不同區(qū)域的鋼樣極性發(fā)生反轉(zhuǎn)。李曉剛等利用微電極陣列技術(shù)探究了海水/海泥界面及其附近區(qū)域電化學信息分布的變化規(guī)律,并聯(lián)合電化學阻抗和線性極化技術(shù)研究發(fā)現(xiàn),海水/海泥界面區(qū)域合金的腐蝕受海泥阻抗、溶解氧濃度和電位差等多種因素控制。
結(jié)語及展望
(1)微電極陣列技術(shù)能夠較準確地獲得局部腐蝕電位、電流密度分布等信息,被廣泛應(yīng)用于諸多領(lǐng)域的局部腐蝕機理研究。
相比于常規(guī)的電化學測試方法,微電極陣列技術(shù)一方面因其掃描速度快、實驗數(shù)據(jù)同步性高、有利于更直觀地研究合金表面局部位置腐蝕變化規(guī)律等優(yōu)點而得到廣泛應(yīng)用;另一方面因其是一種基于底部而非表面的新型測試方法,腐蝕測試沒有其他的微區(qū)電化學測試技術(shù)對合金表面平整度的嚴苛要求,而且它可以以任何給定的圖案、比例排列成不同的微電極陣列,因此適用于獲取具有復雜表面腐蝕狀態(tài)的合金界面電化學分布特征。微電極陣列技術(shù)現(xiàn)已作為一種新型的微區(qū)電化學測試方法,被廣泛用于多種合金局部腐蝕的研究。
然而,微電極陣列技術(shù)也存在一些不足:微電極陣列的分辨率相對較低,影響了該技術(shù)對合金局部腐蝕的表征精度;微電極陣列技術(shù)目前僅局限于測試合金局部腐蝕的電位、電流分布,所能獲取的電極/溶液界面信息較少,進一步分析合金腐蝕界面的電化學信息受到限制;微電極陣列試樣制備工藝比較復雜,容易引起縫隙腐蝕等干擾問題。
(2)微電極陣列技術(shù)與其他電化學測量方法相結(jié)合,可獲得更豐富和多尺度的研究合金局部腐蝕機理的電極/溶液界面信息,將成為合金局部腐蝕的重要研究方法。
近年來,一些專家學者不僅在微電極陣列的制作工藝上不斷改進和完善,還通過進一步縮小微電極的截面尺寸及電極間距來提高其測試精度,并嘗試改進微電極陣列或與其他研究手段聯(lián)合開展研究,以豐富其數(shù)據(jù)類型和電極過程動力學信息。將微電極陣列技術(shù)與電化學阻抗技術(shù)相結(jié)合,可以依靠微電極陣列獲取陰極、陽極腐蝕電流的分布特征,再根據(jù)電流分布情況檢測對應(yīng)區(qū)域的局部阻抗,從而通過電流分布和電化學阻抗的演變來研究合金的腐蝕過程。例如,蘇景新等成功采用微電極陣列技術(shù)聯(lián)合電化學阻抗譜技術(shù)對Q235碳鋼在中性模擬海水中的縫隙腐蝕行為進行研究。
(3)微電極陣列技術(shù)與其他表面科學技術(shù)耦合的研究方法一方面彌補了單一陣列電極技術(shù)獲取界面信息少的缺點,另一方面也為研究界面物理和化學過程提供了新思路。
將微電極陣列與SKP(掃描Kelvin探針)技術(shù)相結(jié)合,可以精確劃分出微電極陣列的網(wǎng)狀分布和排列,進一步細化微電極陣列的尺寸,提高其測試精度,從而彌補微電極陣列在空間分辨率上的不足。Shi等將微電極陣列技術(shù)與拉曼光譜技術(shù)聯(lián)合使用,分別測量鋼筋混凝土在3%NaCl溶液中和干濕交替兩種不同腐蝕環(huán)境下的電位、電流分布和交流阻抗譜圖,均取得了較好的測試結(jié)果。
(4)開發(fā)多電極陣列傳感器探針和多通道測控儀器可實現(xiàn)局部腐蝕速率實時監(jiān)控,提高了微電極陣列測試技術(shù)的精確度。
隨著耦合多電極陣列和多通道儀器的發(fā)展,已經(jīng)開發(fā)出實時耦合的多電極陣列傳感器(CMAS)探針,并用于局部腐蝕速率的實時測量和陰極保護系統(tǒng)性能的實時監(jiān)測,在局部腐蝕在線監(jiān)/檢測中起到了舉足輕重的作用。現(xiàn)已成功應(yīng)用于合金的混凝土腐蝕、縫隙腐蝕、土壤腐蝕、濃氯化物溶液腐蝕和有機涂層質(zhì)量評估等方面的研究,以及合金在水溶液(模擬海水、冷卻水、低導電率飲用水)、油/水混合物、鹽沉積物、生物沉積物、H2S系統(tǒng)和高溫高壓等環(huán)境中的定量局部腐蝕監(jiān)測。
綜上所述,微電極陣列技術(shù)是一種具有前景的在介微觀尺度下研究合金局部腐蝕過程及機理的表征手段。但在應(yīng)力腐蝕開裂、腐蝕疲勞和轉(zhuǎn)化膜成膜過程等方面微電極陣列技術(shù)尚需耦合其他技術(shù)手段進行一些探索性試驗,進而拓寬該技術(shù)的應(yīng)用領(lǐng)域。
 相關(guān)新聞
相關(guān)新聞